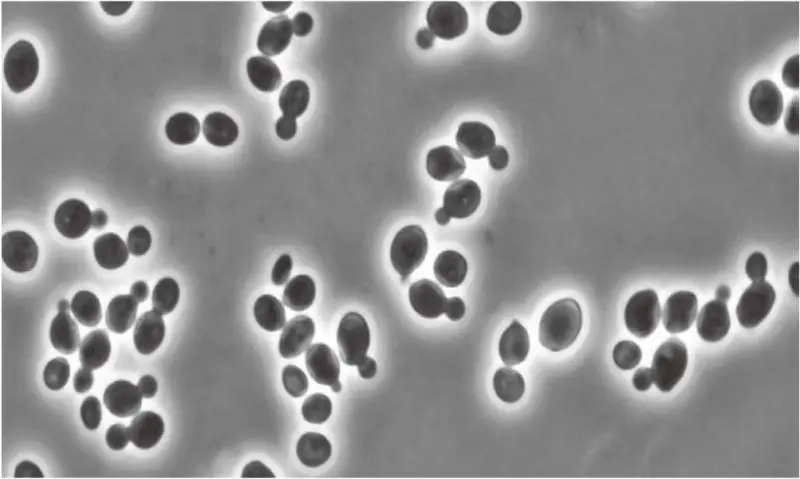

Candida borneonana: International Journal of Systematic and Evolutionary Microbiology 62: 2303–2306, 2012 DOI: 10.1099/ijs.0.039412-0039412-0.


Morphology of strain 11-487T. (a) Colony morphology on YPGA after 1 month of incubation at 25 °C. (b) Cells in a 3-day culture growing in YPGL at 25 °C. (c) Cell groups and pseudohyphae-like cell chains in an overnight culture growing in YPGL at 25 °C. Bar, 10 μm.
Candida citri: FEMS Yeast Res. 11:202-208, 2011 DOI: 10.1111/j.1567-1364.2010.00708.
Candida stigmatis: FEMS Yeast Res. 10: 362–365, 2010 DOI:10.1111/j.1567-1364.2009.00574.
Candida verbasci: Antonie Van Leeuwenhoek. 103:567-576, 2013 DOI: 10.1007/s10482-012-9841-9.
Candida vulturna: International Journal of Systematic and Evolutionary Microbiology, 66:4009-4015, 2016 DOI: 10.1099/ijsem.0.001302.
Candida zemplinina: International Journal of Systematic and Evolutionary Microbiology, 53:2079- 2083, 2003 DOI: 10.1099/ijs.0.02649-0.
Hannaella siamensis: International Journal of Systematic and Evolutionary Microbiology, 65:1297-303, 2015 DOI: 10.1099/ijs.0.000101

Micrograph of budding cells of Hannaella siamensis sp. nov. (DMKU-RP72 T) in YM broth after 3 days at 25 °C. Bar, 10 μm.
Jaminaea angkorensis: International Journal of Systematic and Evolutionary Microbiology, 59:914-920, 2009 DOI: 10.1099/ijs.0.003939-0.

Microscopic morphology of strain C5b T (Jaminaea angkorensis gen. nov., sp. nov.). (a) Budding yeast cells propagating in the liquid medium YPG. (b) Invasive septate hypha branching at a septum. (c) Hyphae producing apical conidia-like cells (marked by arrows). (d and e) Pseudo-hypha-like chains of budding yeast cells establishing satellite yeast colonies at the tips of invasive hyphae. Bar, 10 μm.
Metahyphopichia laotica: International Journal of Systematic and Evolutionary Microbiology, 66:2550-2557, 2016 DOI: 10.1099/ijsem.0.001091.
Metschnikowia laotica: International Journal of Systematic and Evolutionary Microbiology, 64:1847-1852, 2014 DOI: 10.1099/ijs.0.061796-0.
Pichia bruneiensis: International Journal of Systematic and Evolutionary Microbiology 62:3099-3104, 2012 DOI: 10.1099/ijs.0.044974-0.
Starmerella caucasica: J Gen Appl Microbiol. 59(1):67-73, 2013 DOI: https://doi.org/10.2323/jgam.59.67.
a., b.,
Morphology of Starmerella caucasica 11-1071.1T. (a) Colony morphology on YPGA after 1 month of incubation at 25oC. (b) Yeast cells in overnight culture growing in YPGL at 25oC. Scale bar is 5 μm.
Starmerella syriaca: Antonie Van Leeuwenhoek. 107:847-856, 2015 doi: 10.1007/s10482-015-0377-7.
Wickerhamomyces orientalis: International Journal of Systematic and Evolutionary Microbiology, 66:2534-2539, 2016 DOI:10.1099/ijsem.0.001096